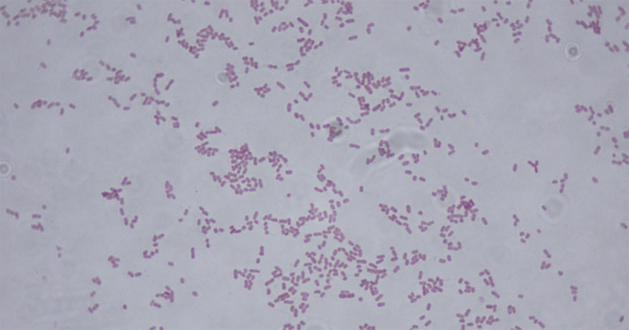

31 Temmuz 2024
2024 yılının başlarında, Dünya Sağlık Örgütü (DSÖ), birkaç ülkenin karbapeneme dirençli hipervirulan Klebsiella pneumoniae (hvKp) olarak tanımlanan izolatlarda artış bildirmesi sebebiyle bilgi talebinde bulundu. Talebe yanıt veren 43 ülkeden 16’sının hvKp’nin varlığını bildirmesinin ardından DSÖ tarafından uyarı yayımlandı.
Klasik Klebsiella pneumoniae’nın aksine, esas olarak hastanede yatan hastalarda gelişen hvKp sağlıklı insanları infekte eder ve sıklıkla ciddi veya ölümcül sonuçlar doğurur. DSÖ’nün değerlendirmesinde genellikle tedavide son basamak kabul edilen bir ilaç grubu olan karbapenem antibiyotiklerine dirençli, dizi tipi ST23 olarak bilinen bir hvKp suşunun yükselişine de dikkat çekildi.
Arjantin, Avustralya, Kanada, Hindistan, Tayland ve Birleşik Krallık dahil olmak üzere 12 ülke tarafından özellikle ST23-K1 suşunun varlığı bildirildi.
DSÖ değerlendirmesinde riski “orta” olarak sınıflandırdı. Hastalığın teşhisi ve yayılmasının izlenmesindeki zorluklar göz önüne alındığında gerçek infeksiyon ve hastane yatış sayılarına ilişkin verilerde bir boşluk olabileceği de raporda belirtildi.